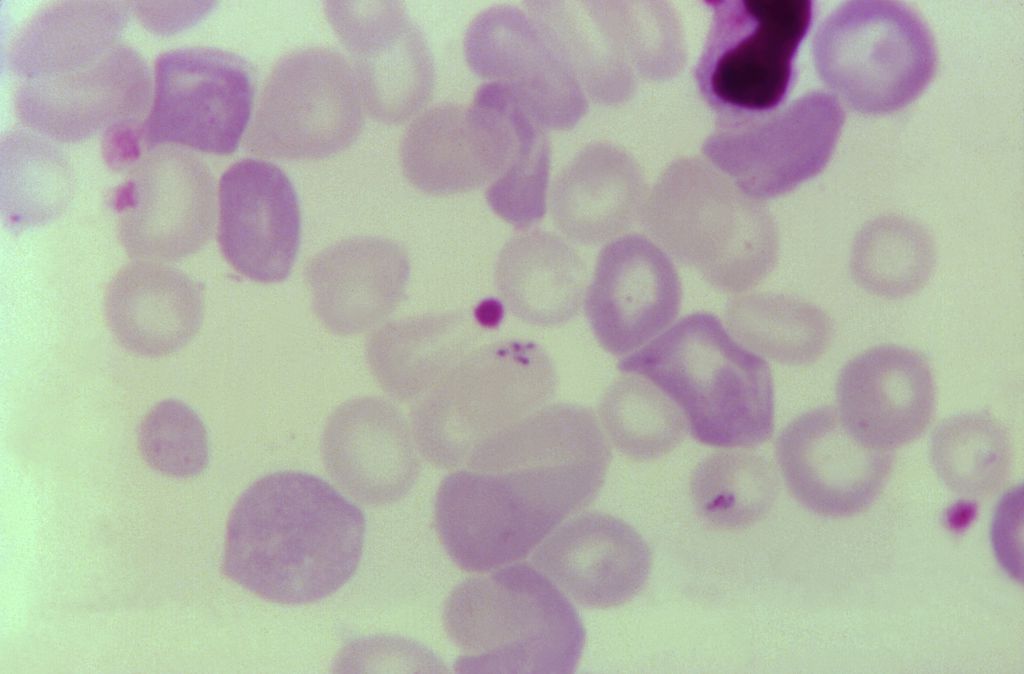

This story was originally published by Grist. Sign up for Grist’s weekly newsletter here.
Ellen Stromdahl was at a garden party in coastal Virginia in June 2023 when her friend Albert Duncan stood up from where he was sitting and abruptly fainted. Duncan is an outdoorsman in his mid-80s — still active and healthy for his age. Stromdahl, an entomologist who works for the United States Army Public Health Center, the Army’s public health arm, rushed to his side. As Duncan came to, she noticed that his tanned skin was tinged with yellow. “This man looks jaundiced,” she thought to herself.
Duncan spent the next several days in and out of the emergency room. His doctors administered countless blood tests and ruled out the usual suspects for an octogenarian — heart disease, diabetes, pneumonia. Finally, on Stromdahl’s recommendation, Duncan’s wife, Nancy, asked his doctors to test him for babesiosis, a rare malaria-like disease caused by microscopic parasites carried by black-legged ticks. The test came back positive not just for babesiosis but also for Lyme disease, another far more common illness caused by the same type of tick.
If Duncan’s doctors had caught the infections sooner, they could have eradicated them with a combination of oral antibiotics and antiparasitic medications. But Duncan, weeks into his illness, needed a procedure called an exchange transfusion. Doctors pumped all of the infected blood out of his body and replaced it with donor blood. About two weeks after the garden party, he was well again.
Babesiosis is rare — the Centers for Disease Control and Prevention reports around 2,000 cases in the United States every year. But what made Duncan’s case even more unusual is that he contracted babesiosis in Virginia, a state that registered just 17 locally acquired cases of the disease between 2016 and 2023.
It got Stromdahl wondering if babesiosis could be becoming more common in Virginia and neighboring states. She spent the following two years working with a team of 21 tick researchers from across the eastern U.S. and South Africa to assess the prevalence of Babesia microti, the parasite that causes babesiosis, in ticks and humans in those states from 2009 to 2024.
The results of the study, published in April in the Journal of Medical Entomology, reveal that the Babesia parasite is rapidly expanding through the mid-Atlantic. This shift, which has coincided with changing weather patterns, could pose a serious threat to people in communities where the disease has long been considered rare.
“Wherever we found positive ticks, there were cases,” Stromdahl said. “They’re small numbers, but that’s why we want to give the early warning before more people get sick.”
Smith Collection / Gado / Getty Images Smith Collection/Gado
One in four cases of babesiosis is asymptomatic. People who do develop symptoms, especially older adults and immunocompromised people, can get quite sick with fever, chills, anemia, fatigue, and jaundice. Untreated, the parasites, which infect and destroy red blood cells, can lead to organ failure and death.
Babesiosis is typically found in the Northeast and the Upper Midwest. Between 2015 and 2022, case counts in the states that regularly report the disease — Connecticut, Massachusetts, Minnesota, New Jersey, New York, Rhode Island, and Wisconsin — rose by 9 percent every year, a development researchers attribute in large part to warmer temperatures caused by climate change, which afford black-legged ticks more opportunities to bite people in a given year and more habitat to spread into.
Climatic conditions in the southern mid-Atlantic have always been welcoming for ticks, but warmer-than-average winters that have been occurring with grim regularity in recent years are turning some states in the region into year-round breeding sites for ticks and small rodents like mice, chipmunks, and shrews — the critters that carry Lyme bacteria and the Babesia parasite in their blood. Above-normal annual rainfall, which saturates the soil and adds to overall humidity in the region, also encourages the proliferation of ticks. The 2023 to 2024 winter season across much of the mid-Atlantic was 4 to 6 degrees Fahrenheit warmer than normal, and many states had some of their wettest Decembers and Januaries on record.
Stromdahl has been studying the movement of ticks and the diseases they carry for decades. She’s seen it all — including the northward spread of the Lone Star tick, which can impart a lifelong, sometimes deadly reaction to red meat. But even she was shocked to discover how far the Babesia parasite had spread.
She and her co-authors collected 1,310 ticks in Virginia, Maryland, and Delaware and found the B. microti parasite in all three states, indicating that there is potential for more human cases across the southern mid-Atlantic. None of those states had ever found the parasite in ticks before.
Many of the ticks the authors looked at were also infected with the bacteria that causes Lyme disease. The Lyme-babesiosis connection is an active area of research. Experts suspect ticks infected with one of the diseases are more predisposed to be infected with the other, but they still don’t know why exactly. What they do know is that Lyme is a harbinger of babesiosis. Previous studies on tick-borne illness found that areas that saw rising cases of Lyme disease from the 1980s to the early 2000s reported more babesiosis cases one to two decades later.
“The findings in the Stromdahl paper are consistent with what we’ve seen in the Northeast: Babesia infection seems to spread where Lyme infection is already present,” said Shannon LaDeau, a disease ecologist at the Cary Institute of Ecosystem Studies who was not involved in the study.
The authors also examined where human cases of babesiosis were clustered. Of particular concern were two hot spots: the five counties surrounding and encompassing the city of Baltimore and the Delmarva Peninsula — an 180-mile-long coastal landmass comprising parts of Delaware, Maryland, and Virginia. Fifty-five percent of Maryland’s cases were from the Baltimore area, and some 38 percent of cases from Virginia, Maryland, West Virginia, and the District of Columbia combined were from the Delmarva Peninsula.
Experts believe babesiosis cases are severely underreported due to a lack of physician awareness. Stromdahl and her colleagues hope their findings will inspire health departments in the mid-Atlantic to recognize that babesiosis is a growing concern, conduct surveillance for infected ticks, and put out public health warnings. If doctors in the region know to test for babesiosis, severe cases like Duncan’s can be avoided.
“Jurisdictions in the southern mid-Atlantic region should expect babesiosis cases,” the authors warn. “Tick range expansion is occurring at such a precipitous rate that public health guidance regarding tick-borne disease prevention and treatment can be rapidly rendered obsolete.”
Climate change isn’t the only environmental factor driving the rising density and expansion of tick populations. Efforts over the past few decades to reforest barren areas have encouraged herds of white-tailed deer, animals that pick up ticks and carry them miles before the arachnids drop off into the leaf litter, to proliferate. Declining rates of recreational and subsistence hunting are adding to deer overpopulations. At the same time, an ongoing expansion of suburban development into forested zones is putting more people in contact with ticks and the diseases they carry.
“The most important take-home is that tick-borne disease is a growing risk,” LaDeau said. The big question as tick populations increase, she added, is to figure out where and when infected ticks overlap with people. “There is still a huge need for data to understand how often these infected ticks come into contact with humans.”
This article originally appeared in Grist at https://grist.org/health/babesiosis-mid-atlantic-delaware-maryland-virginia-tick-borne-disease-lyme-research/.
Grist is a nonprofit, independent media organization dedicated to telling stories of climate solutions and a just future. Learn more at Grist.org